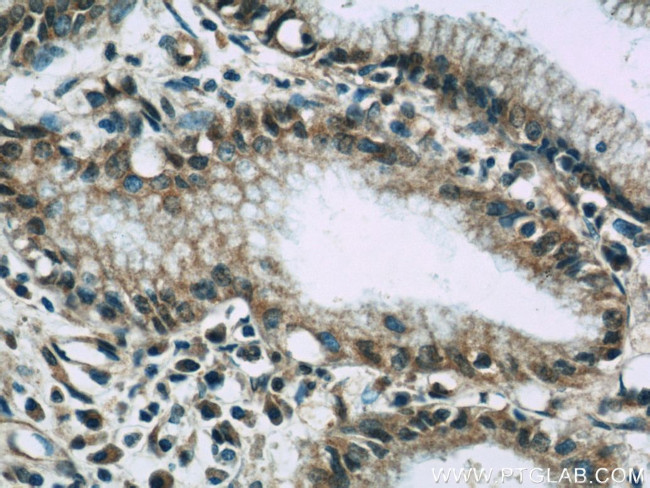
VNN1 Antibody in Immunohistochemistry (Paraffin) (IHC (P))

Search
Proteintech
VNN1 Polyclonal Antibody
{{$productOrderCtrl.translations['antibody.pdp.commerceCard.promotion.promotions']}}
{{$productOrderCtrl.translations['antibody.pdp.commerceCard.promotion.viewpromo']}}
{{$productOrderCtrl.translations['antibody.pdp.commerceCard.promotion.promocode']}}: {{promo.promoCode}} {{promo.promoTitle}} {{promo.promoDescription}}. {{$productOrderCtrl.translations['antibody.pdp.commerceCard.promotion.learnmore']}}
产品信息
21745-1-AP
种属反应
已发表种属
宿主/亚型
分类
类型
抗原
偶联物
形式
浓度
规格
纯化类型
保存液
内含物
保存条件
运输条件
产品详细信息
Immunogen sequence: SQLDSHPSH SAVVNWTSYA SSIEALSSGN KEFKGTVFFD EFTFVKLTGV AGNYTVCQKD LCCHLSYKMS ENIPNEVYAL GAFDGLHTVE GRYYLQICTL LKCKTTNLNT CGDSAETAST RFEMFSLSGT FGTQYVFPEV LLSENQLAPG EFQVSTDGRL FSLKPTSGPV LTVTLFGRLY EKDWASNASS GLTAQARIIM LIVIAPIVCS LSW (302-513 aa encoded by BC096268)
靶标信息
Hematopoietic precursor cells migrate to the thymus, where they differentiate into mature T lymphocytes. GPI-anchored vanin-1 protein regulates the late adhesion steps of thymus homing of bone marrow precursor cells. Vanin-1 is ubiquitously expressed as a pantetheinase enzyme and catalyzes the hydrolysis of pantetheine for vitamin B5 recycling. The hydrolytic activity of vanin-1 generates the potent antioxidant cysteamine as a metabolite. As a membrane bound pantetheinase, vanin-1 provides the main source of cysteamine under normal physiological conditions. In mice, vanin-1 is expressed specifically in male Sertoli cells of the developing testis, where it aids in cell migration.
仅用于科研。不用于诊断过程。未经明确授权不得转售。
生物信息学
蛋白别名: Pantetheinase; Pantetheine hydrolase; Tiff66; unnamed protein product; Vanin-1; Vanin1; vannin 1; Vascular non-inflammatory molecule 1
基因别名: HDLCQ8; Tiff66; V-1; VNN1
UniProt ID: (Human) O95497, (Mouse) Q9Z0K8
Entrez Gene ID: (Human) 8876, (Mouse) 22361